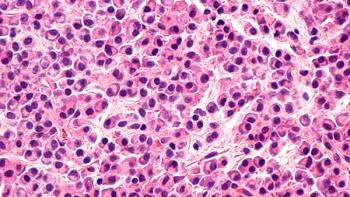

Investigators hope the results will increase public support for prescribed fires that help maintain forest health and prevent wildfires.

Investigators hope the results will increase public support for prescribed fires that help maintain forest health and prevent wildfires.

A group of pediatric patients were able to sustain desensitization 4 weeks after stopping the daily oral immunotherapy.

Investigators also identified 3 distinct phenotypes that contribute to hospitalized patients with acute asthma exacerbation.

How far in advances of care have we come, what issues are most pressing in the field now, and what specialties with be involved in future meetings?

The introduction of biologics such as dupilumab have opened avenues of care for patients with overlapping disease.

The biologic's indications for inflammatory diseases are greatly varied and still developing, and it owes some of that to recent advances in disease prognosis.

The AAAAI 2019 president explains why research is already dedicated toward improving investigative peanut allergens.

The Regeneron VP explains how dupilumab could possibly serve as a complimentary therapy to Aimmune's investigative food allergy therapy.

Results showed a statistically significant difference in responder rate between active treatment and placebo but didn’t meet a prespecified threshold for clinical significance.

The Program Chair explains how the meeting has improved over 3 decades, and highlights his favorite sessions to come at the 2019 meeting.

Investigators also found that opiate agonist therapy could have a positive effect in limiting reinfection rates after patients achieve SVR.

Mohamad Mohty, MD, PhD, discusses the investigational therapy cytotoxic T lymphocytes (CTLs) therapy for the treatment of Epstein-Barr virus associated post-transplant lymphoproliferative disorder (EBVPTLD).

An early prophylaxis in combination with an assistant device like myPKFit can improve the outcomes of treatment.

For patients with chronic liver disease, opioid prescriptions are common, and high-risk prescriptions are associated with hepatic decompensation, especially ascites.

This rare leukemia form may be treated with ruxolitinib, which appears to be well-tolerated by patients.

Patients with myeloproliferative neoplasms (MPN) with essential thrombocythemia (ET) or polycythemia vera (PV) were found to benefit from hydroxyurea therapy.

Patients with myeloid/lymphoid neoplasms enrolled in the phase 2 clinical trial demonstrated pemigatinib was generally well-tolerated.
Nizar Bahlis, MD, highlights the phase 3 POLLUX trial evaluating daratumumab plus lenalidomide and dexamethasone for the treatment of patients with relapsed/refractory multiple myeloma.

ALD-related hospitalizations grew from 2008 to 2014, especially among women, Asians, Hispanics, and people 50 to 69 years of age.

No studies to-date have looked at the combined risk of mortality for patients with thrombocytopenia and severe hepatic steatosis.

The leading etiologies for chronic-liver-disease-related-deaths over the last decade can be explained by NAFLD and alcoholic liver disease.

A new study confirms that HCV-RNA can be found in the nasal and rectal fluids of patients with high viral loads of HCV, raising the possibility of HCV transmission via these fluids.

A low dose of TDF may help to preserve renal function and maintain viral suppression in patients with chronic hepatitis B virus infection, even those with advanced liver disease.

Among the highlights, significant and sustained increases in hemoglobin without transfusions stood out.

Lead investigator, John Leonard, MD, reviews the phase 3 AUGMENT trial investigating lenalidomide plus rituximab for the treatment of relapsed/refractory follicular lymphoma.

Models show that for every gram of hemoglobin increased per deciliter, the risks associated with hemolytic anemia decrease.

Jorge Cortes, MD, highlights the phase 3 QuANTUM-R trial results and explains their clinical implications for patients with FLT3-ITD-mutated relapsed/refractory acute myeloid leukemia (AML).

After the therapy was approved by the FDA in May, investigators are anticipating its first real-world data will paint a clearer picture of its potential.

Patients’ daily bleed diaries helped investigators understand why some bleeds are treated, and some are not, as well as their causes.

Jasmine Zain, MD, recaps the current and upcoming treatments in T-cell lymphoma and highlights the key clinical trials playing a role in the rare disease.